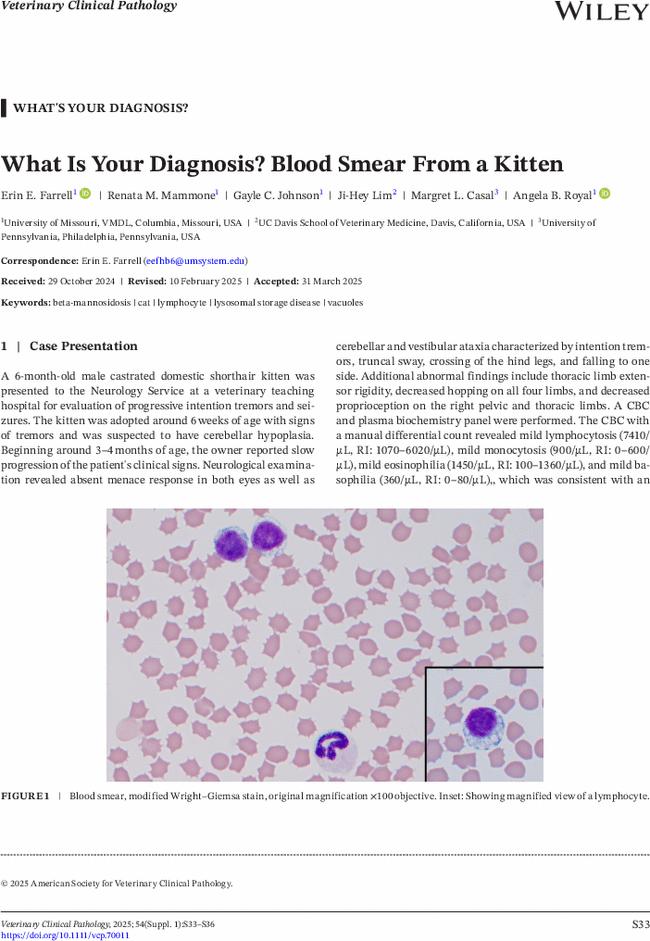

你的诊断是什么?小猫的血涂片。
IF 1.1
4区 农林科学
Q3 VETERINARY SCIENCES
引用次数: 0
摘要
本文章由计算机程序翻译,如有差异,请以英文原文为准。
What Is Your Diagnosis? Blood Smear From a Kitten
求助全文
通过发布文献求助,成功后即可免费获取论文全文。
去求助
来源期刊

Veterinary clinical pathology
农林科学-兽医学
CiteScore
1.70
自引率
16.70%
发文量
133
审稿时长
18-36 weeks
期刊介绍:
Veterinary Clinical Pathology is the official journal of the American Society for Veterinary Clinical Pathology (ASVCP) and the European Society of Veterinary Clinical Pathology (ESVCP). The journal''s mission is to provide an international forum for communication and discussion of scientific investigations and new developments that advance the art and science of laboratory diagnosis in animals. Veterinary Clinical Pathology welcomes original experimental research and clinical contributions involving domestic, laboratory, avian, and wildlife species in the areas of hematology, hemostasis, immunopathology, clinical chemistry, cytopathology, surgical pathology, toxicology, endocrinology, laboratory and analytical techniques, instrumentation, quality assurance, and clinical pathology education.
 求助内容:
求助内容: 应助结果提醒方式:
应助结果提醒方式:


